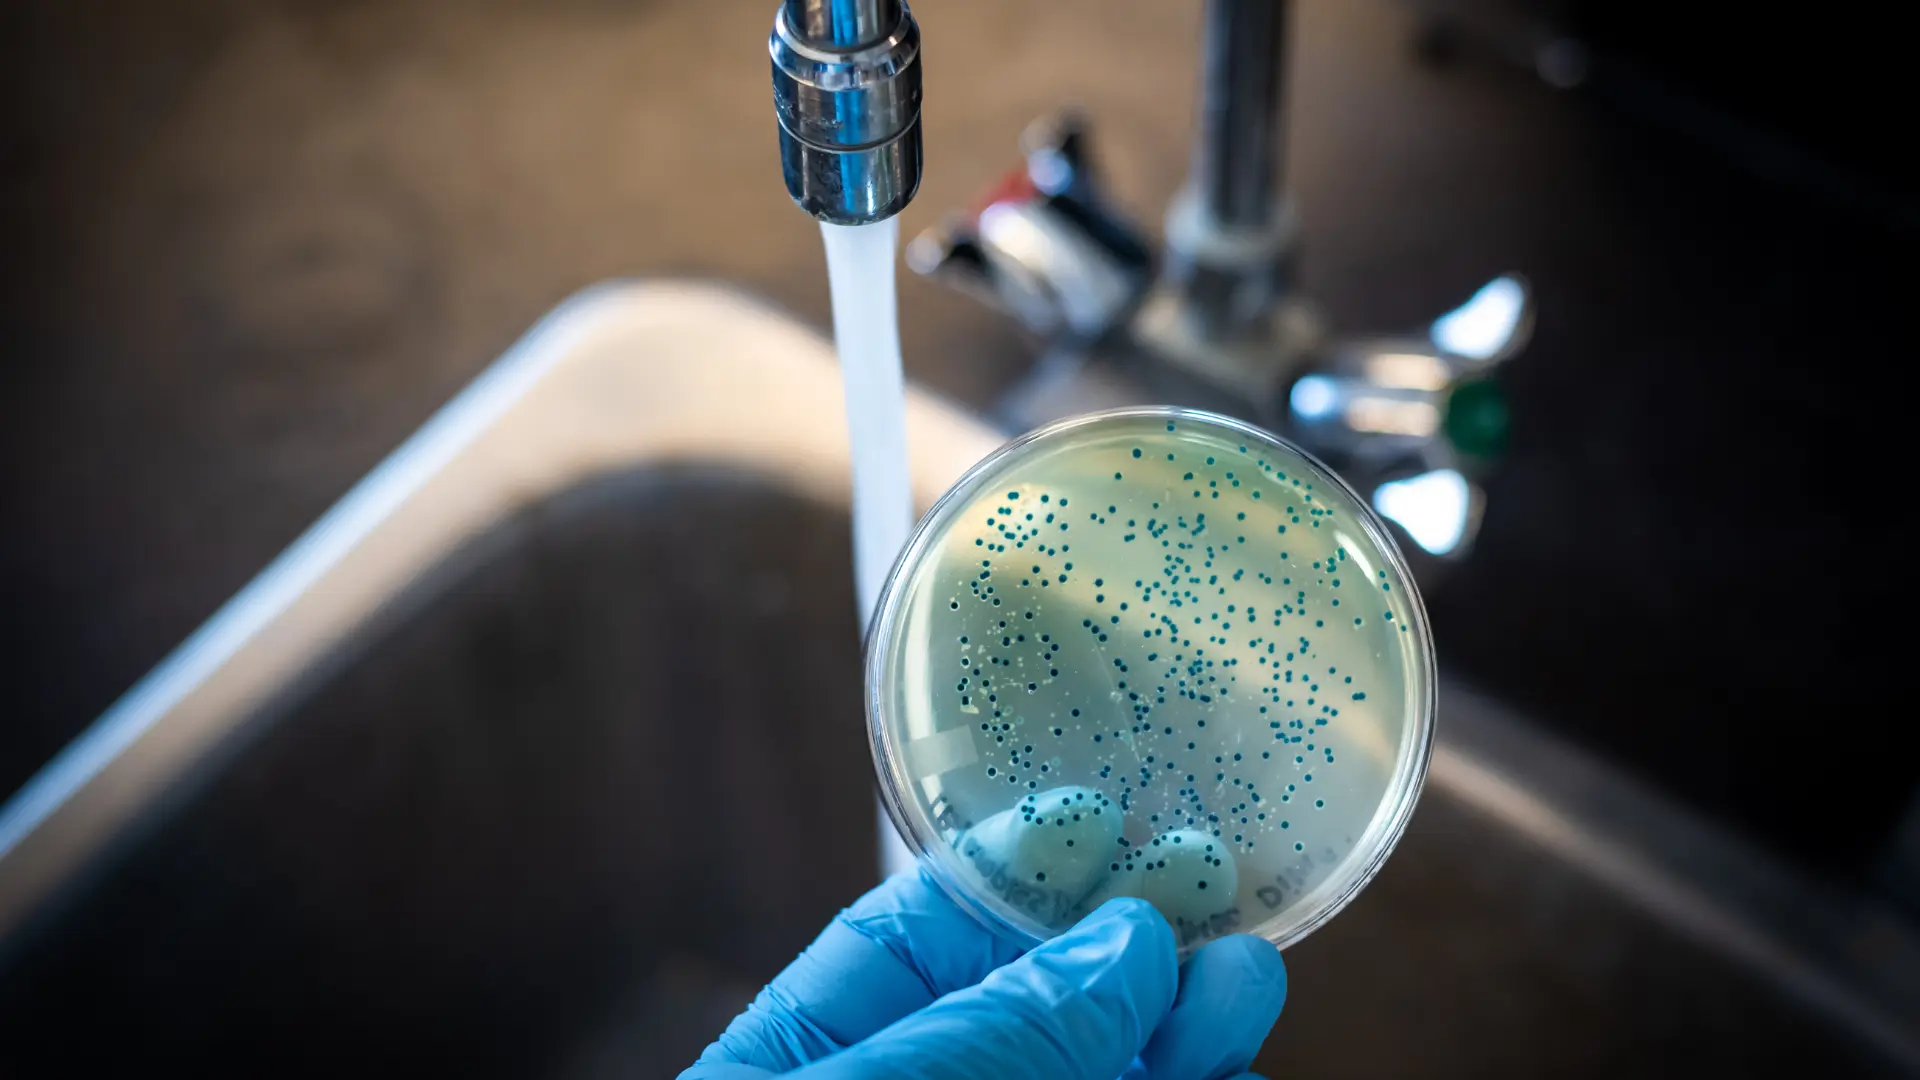
What to Do If Well Water Is Contaminated

Well Water Testing Blog & Guides
Practical, easy-to-understand articles to help private well owners learn about well water testing, testing requirements, and how to keep their water safe.
Well water testing blog articles
Well Water Testing: Essential Knowledge for Private Well Owners
Private well owners face unique responsibilities when it comes to water quality. Unlike municipal water systems regulated by the Environmental Protection Agency (EPA), private wells are not subject to federal monitoring requirements. This means well owners must take the initiative to test their water regularly and understand what those tests mean. The Centers for Disease Control and Prevention (CDC) recommends annual testing as a minimum, with additional testing based on your location, well characteristics, and specific circumstances.
Why Well Water Testing Matters
Well water testing is the only reliable way to know if your water is safe to drink. Many contaminants have no taste, odor, or visible appearance, making testing essential rather than optional. The EPA emphasizes that private well owners are responsible for ensuring their water quality because there are no federal regulations requiring monitoring of private wells. Regular testing helps you catch problems early, before they become serious health concerns or expensive repairs.
Testing is particularly important for vulnerable populations, including infants, pregnant women, elderly individuals, and people with compromised immune systems. Some contaminants, like nitrates, pose immediate risks to infants but may not affect healthy adults at the same levels. Others, such as arsenic or lead, cause health effects from long-term exposure, making regular testing crucial for detecting problems before they cause harm.
Understanding Well Water Testing Requirements
The CDC recommends annual testing for total coliform bacteria and nitrates as a baseline for all private wells. Beyond that, testing frequency and what to test for depends on several factors. Your geographic location matters because different regions have different natural contaminants. Areas with agricultural activity may need more frequent nitrate testing, while regions with certain geology may need radon or arsenic testing. Your well's construction and age also influence testing needs.
Real estate transactions often require comprehensive water testing that includes bacteria, nitrates, lead, arsenic, and other contaminants depending on state requirements. Some lenders require water test results before approving loans for properties with private wells. Testing after flooding, heavy rain, or well repairs is also recommended because these events can introduce contamination. If you notice changes in water taste, odor, color, or if anyone in your household experiences unexplained illness, test your water promptly.
How to Choose the Right Well Water Tests
Selecting appropriate tests starts with understanding your situation. For routine annual testing, begin with bacteria and nitrates as the CDC recommends. Then consider your location: check with your local health department about contaminants of concern in your area. Agricultural regions often need pesticide testing, while areas with certain rock types may need radon or uranium testing. If you're buying or selling a home, check state requirements for real estate transactions.
Test panels vary by laboratory and can range from basic screening to comprehensive analysis. Basic panels typically include bacteria, nitrates, pH, and hardness. More comprehensive panels add metals like arsenic and lead, radiological contaminants like radon and uranium, and agricultural chemicals like pesticides. PFAS testing requires specialized panels and is more expensive. Work with a certified laboratory to choose tests appropriate for your circumstances and budget.
Where to Get Well Water Tested
The CDC recommends using state-certified laboratories for well water testing to ensure accurate results that are accepted for official purposes like real estate transactions. Certified labs follow strict quality control procedures and their results are reliable. You can find certified laboratories through your local health department, state environmental agency, or by using our directory of well water testing providers organized by state and city.
Some laboratories offer field sampling services where they come to your home to collect samples, while others provide mail-in kits or require you to bring samples to their facility. Field services are convenient but typically more expensive. Mail-in kits work well for basic testing if you can follow collection instructions carefully. In-person drop-off ensures samples reach the lab quickly, which is important for time-sensitive tests like bacteria.
Understanding Well Water Test Results
Interpreting well water test results requires understanding reference levels and what they mean for your health. Results are typically compared to EPA Maximum Contaminant Levels (MCLs) and Health Advisory levels, even though private wells aren't regulated by these standards. These reference levels help you understand whether your results indicate a health concern requiring action.
For example, the EPA MCL for nitrates is 10 mg/L, and levels above this pose risks to infants. Arsenic has an MCL of 0.010 mg/L (10 parts per billion), and long-term exposure above this level increases cancer risk. Total coliform bacteria should be absent—any detection suggests your well may be vulnerable to contamination. Your lab report should explain how your results compare to these reference levels and whether any detected contaminants require action.
Finding Reliable Well Water Testing Services
Finding a certified laboratory or testing service is the first step toward ensuring your well water is safe. The CDC recommends contacting your local health department for a list of state-certified laboratories in your area. Our directory helps you find testing providers organized by state and city, making it easier to locate certified laboratories and sampling services near you. Look for laboratories certified by your state's department of health or environmental agency to ensure results are reliable and accepted for official purposes.
When comparing testing providers, consider their certifications, available test panels, turnaround times, and pricing. Ask about their experience with well water testing specifically, as some labs focus primarily on municipal water systems. Verify they're certified for the specific contaminants you need tested, as not all labs are certified for all types of analysis. Our articles provide detailed guidance on choosing testing providers and understanding the differences between labs, field services, and treatment companies. Browse our state-by-state directory to find certified testing providers in your area.
Frequently Asked Questions about Well Water Testing
Common questions about testing frequency, costs, sample collection, interpreting results, and finding certified laboratories.